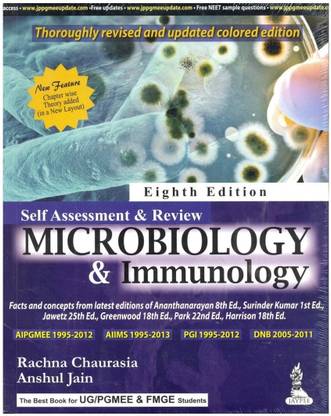
Self Assessment & Review Microbiology & Immunology

Self Assessment & Review Microbiology & Immunology (English, Paperback, Chaurasia Rachna)
- Language: English
- Binding: Paperback
- Publisher: Jaypee Brothers Medical Publishers
- Genre: Medical
- ISBN: 9789350907290, 9789350907290
Self Assessment & Review Microbiology & Immunology is a comprehensive book for undergraduate medical students. The book covers all facts and concepts of microbiology and immunology. In addition, the book consists of previous years’ solved papers of various postgraduate medical entrance exams. This book is essential for medical students aspiring to gain admission in a postgraduate program in one of the leading medical colleges of India.
About the Authors
Dr. Rachna Chaurasia and Dr. Anshul Jain are practicing doctors and academic authors. They have co-authored this book.
| Imprint |
|
- 5★
- 4★
- 3★
- 2★
- 1★
- 20
- 7
- 4
- 0
- 3
excellent
The book is very useful for PGMEE prep, chapters divided to cover all the important microorganisms, with mcqs at the end of each chapter.
srivatsan thirumalai vasu
Certified Buyer, Bangalore
Jun, 2014
A Class Apart
Dr Arnab Naha
Certified Buyer, Kolkata
Aug, 2014
better book
ssn
Certified Buyer, Chennai
Jun, 2014
microbiology at its best
Dr.Souvagya Kar
Certified Buyer, Cuttack Sadar
Jun, 2014
Best book for microbiology
well presented
contains good number of questions with explanations
must read book for AIPG entrance to answer microbiology questions with confidence
Sri Satya
Certified Buyer, Kottayam
Jun, 2014




